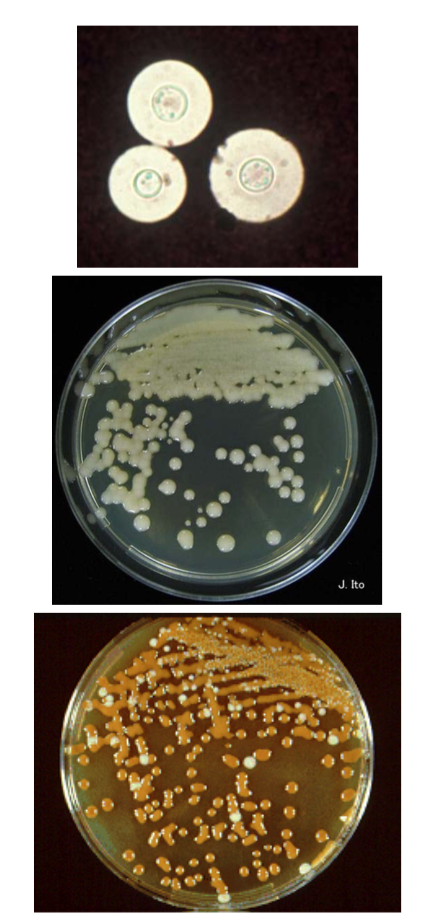
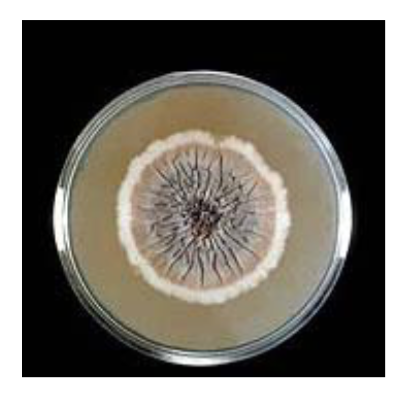
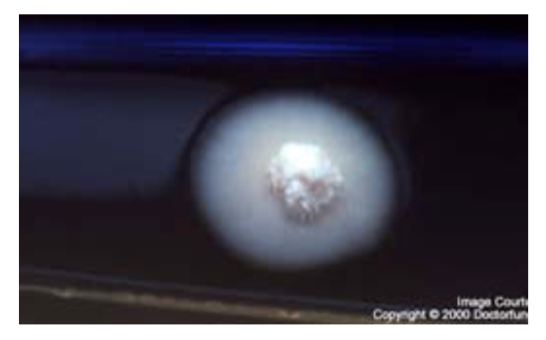
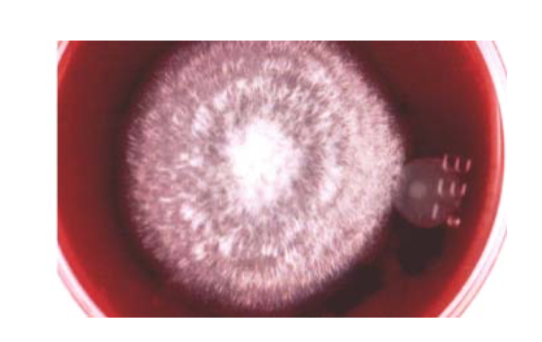
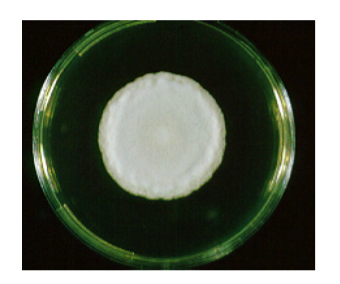

Candida albicans
Cause

Candida albicans

Candida albicans

Cryptococcus

Cryptococcus neoformans
Cryptococcus neoformans

Malassezia
Cause

Sporothrix schenkii

Sporothrix schenkii
Sporothrix schenkii

Blastomyces dermatitidis

Blastomyces dermatitidis
Blastomyces dermatitidis
Coccidioides immitis

Coccidioides immitis

Histoplasma capsulatum var capsulatum

Histoplasma capsulatum var capuslatum
Histoplasma capsulatum var capsulatum

Histoplasma capulatum var farciminosum

Histoplasma capsulatum var farciminosum

Oomycetes
Cause

Oomycetes